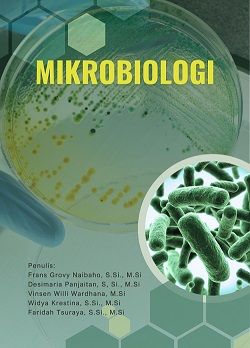
MIKROBIOLOGI

18
May
18
May
18
May
Syarat dan Ketentuan
Buku adalah karya sendiri tidak plagiat Isi buku dapat dipertanggungjawabkan ...
18
May
Menulislah Untuk Sebuah Perubahan
Menulis bukan sekedar menebar karya sebagai pembuktian adanya kemampuan yang ...
25
Feb
PENERAPAN 5S DI KAMPUS
Kesehatan, Keselamatan Kerja ( K3) adalah evaluasi dan pengendalian bahaya yang ...